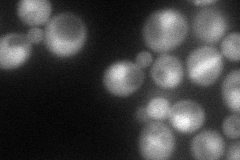
YBL049W
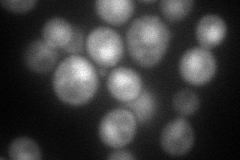
YBL049W
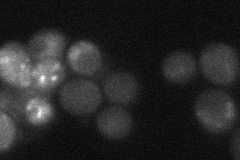
YBL049W
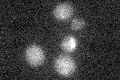
YBL049W

View description
Protein of unknown function, has homology to kinase Snf7p; not required for growth on nonfermentable carbon sources; essential for viability in stationary phase
Localization:
Intensity:
Fold change:
Significance:
-
C’ GFP library in SD

below threshold17.47 -
N' NOP1pr-GFP in SD
cytosol,nucleus83.9878 -
N' TEF2pr-mCherry in SD
punctate,nucleus68.7083 -
N' NATIVEpr-GFP in SD
punctate25.2479 -
N' TEF2pr-VC and Cyto-VN in SD

cytosol28.6084 -
C’ GFP library in SD+DTT

cytosol16.450.94No -
C’ GFP library in SD+H2O2

cytosol15.640.89No -
C’ GFP library in Starvation Media
cytosol16.370.93No -
C’ GFP library on the background of Pup2-DaMP

below threshold -
C’ GFP library on the background of CCT mutant

below threshold16.38710.937242No
